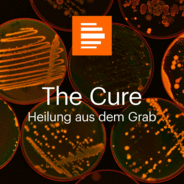
The Cure – Heilung aus dem Grab-Logo

Kultur & GesellschaftWissenschaft & TechnikGesundheit, Wellness & Beauty
The Cure – Heilung aus dem Grab
200 Jahre nach dem Tod eines irischen Priesters und Wunderheilers lässt den Mikrobiologen Gerry Quinn ein Gedanke nicht mehr los. Er ist überzeugt, dass die Graberde des Priesters heilen kann und in ihr die Antwort für eine der größten Herausforderungen der weltweiten Gesundheit liegt: den Kampf gegen multiresistente Keime.
The Cure – Heilung aus dem Grab im Überblick
| Autor | Deutschlandfunk Kultur |
| Sender | Deutschlandfunk Kultur |
| Land | Deutschland |
| Sprache | Deutsch |
Podcast
